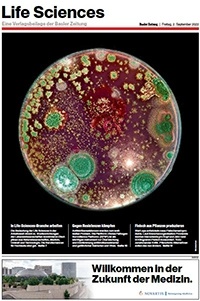
Life Sciences - Sonderbeilage der Basler Zeitung

Life Sciences - Supplément spécial, Basler Zeitung
01 Septembre 2023

Metrobasel Report 2022
Interview de Matthias Leuenberger
Life Sciences - Supplément spécial, Basler Zeitung
02 septembre 2022

Life Sciences - Supplément spécial, Basler Zeitung
03 septembre 2021

Life Sciences - Supplément spécial, Basler Zeitung
04 septembre 2020

Novartis - Gemeinsam in die Zukunft
02 mars 2018
